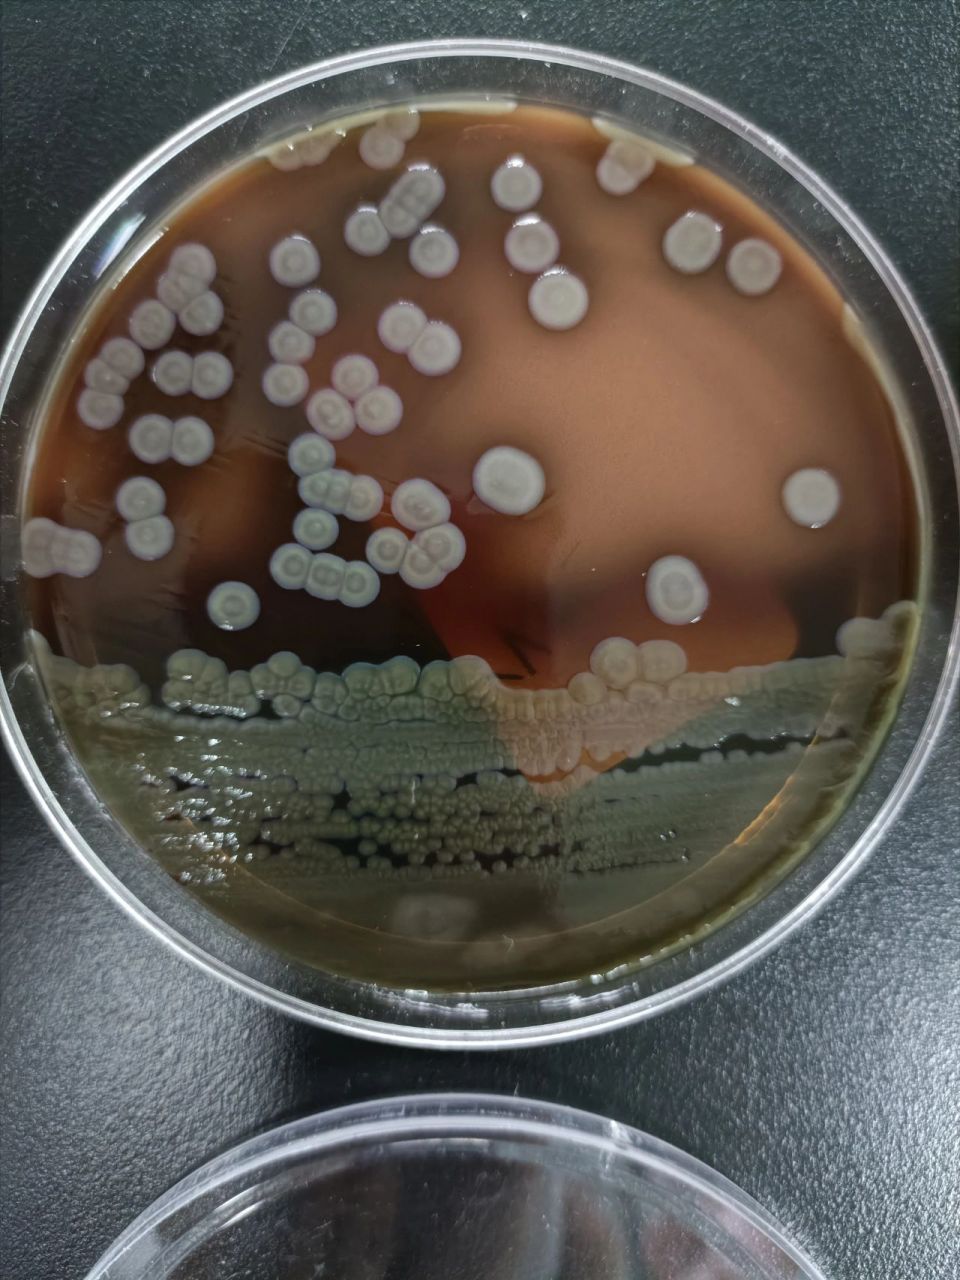
嗜麦芽窄食单胞菌 1.
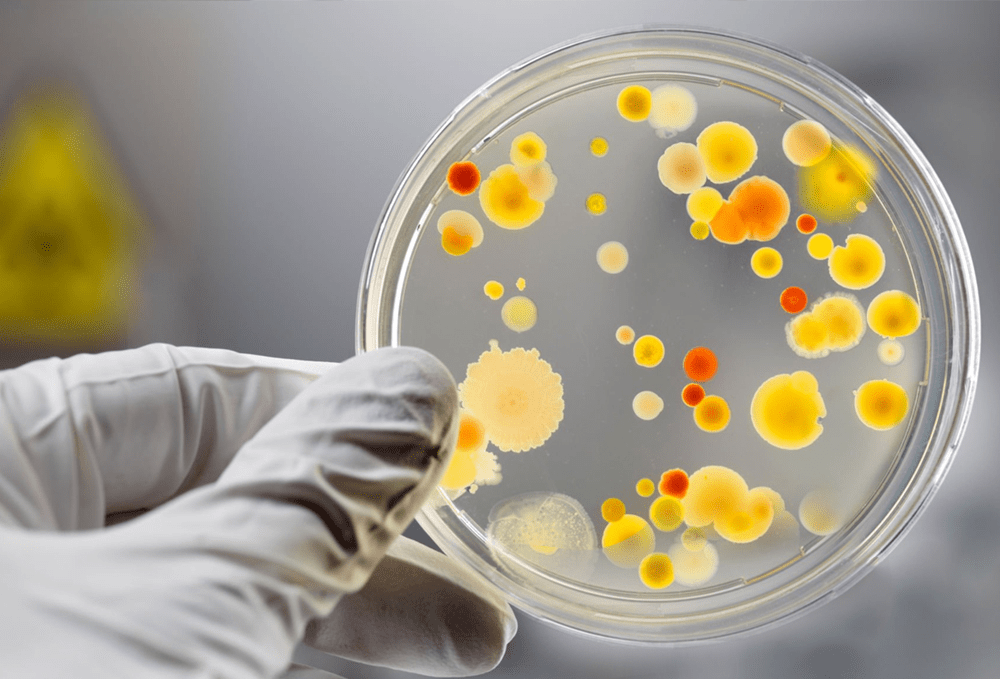
我们该如何应对?_病毒_细菌_患者

h5n1细菌

h5n1禽流感:死亡率直逼52%,我们如何预防可能的大流行?
图片尺寸960x540
美国得州一名男子感染h5n1高致病性禽流感,系首例牛传人病例 | 环球
图片尺寸897x735
h5n1病毒
图片尺寸700x394
h5n1禽流感会成为下一次流感大流行吗?
图片尺寸660x434
美国发现人类感染甲型h5n1流感病毒病例
图片尺寸640x360
h5n1禽流感会成为下一次流感大流行吗?
图片尺寸660x595
嗜麦芽窄食单胞菌 1.
图片尺寸960x1280
h5n1病毒
图片尺寸700x700
【#澳洲女童印度行后感染h5n1型禽流感#】据新华社:世界卫生组织7日说
图片尺寸660x452
h5n1禽流感有可能成新疫情,都是美国人的"倔强"惹的祸?
图片尺寸640x514
how can we reach, treat and cure everyone with tb?
图片尺寸640x350
奶牛h5n1感染人病例持续增加,患者首现流感症状
图片尺寸850x630
羊驼身上首次检测到禽流感病毒
图片尺寸800x450
世卫组织称,一名两岁半女孩前往印度后被检测出感染 h5n1 禽流感病毒
图片尺寸690x388![[左]h5n1 禽流感病毒;[右]可以在哺乳动物雪貂中传染,并造成致命威胁](https://imgs.wantubizhi.com/img/A1A61BAA66193547F3A6DD7D8EE527E957389160A33E576B1B74142D22C5697F47116DA125D93CEE0F5C6471B32C948448632F92FA9C66C560C3912946A17D7D6F649EB997A2E80BE24488E78DB1B5D230623E4A9FF7A0427FB665986F1F2460)
[左]h5n1 禽流感病毒;[右]可以在哺乳动物雪貂中传染,并造成致命威胁
图片尺寸600x276
h5n1禽流感:死亡率直逼52%,我们如何预防可能的大流行?
图片尺寸465x279
我们该如何应对?_病毒_细菌_患者
图片尺寸1000x679
奶牛h5n1感染人病例持续增加,患者首现流感症状
图片尺寸1126x1360
流感h5n1h1n1泛型中细胞结构流体
图片尺寸700x700
1997年,香港出现的甲型h5n1流感病毒,传染源直接或间接接触染病活禽
图片尺寸800x939











![[左]h5n1 禽流感病毒;[右]可以在哺乳动物雪貂中传染,并造成致命威胁](https://imgs.wantubizhi.com/img/A1A61BAA66193547F3A6DD7D8EE527E957389160A33E576B1B74142D22C5697F47116DA125D93CEE0F5C6471B32C948448632F92FA9C66C560C3912946A17D7D6F649EB997A2E80BE24488E78DB1B5D230623E4A9FF7A0427FB665986F1F2460)

![[左]h5n1 禽流感病毒;[右]可以在哺乳动物雪貂中传染,并造成致命威胁](https://1-im.guokr.com/gkimage/6m/6u/6l/6m6u6l.png)